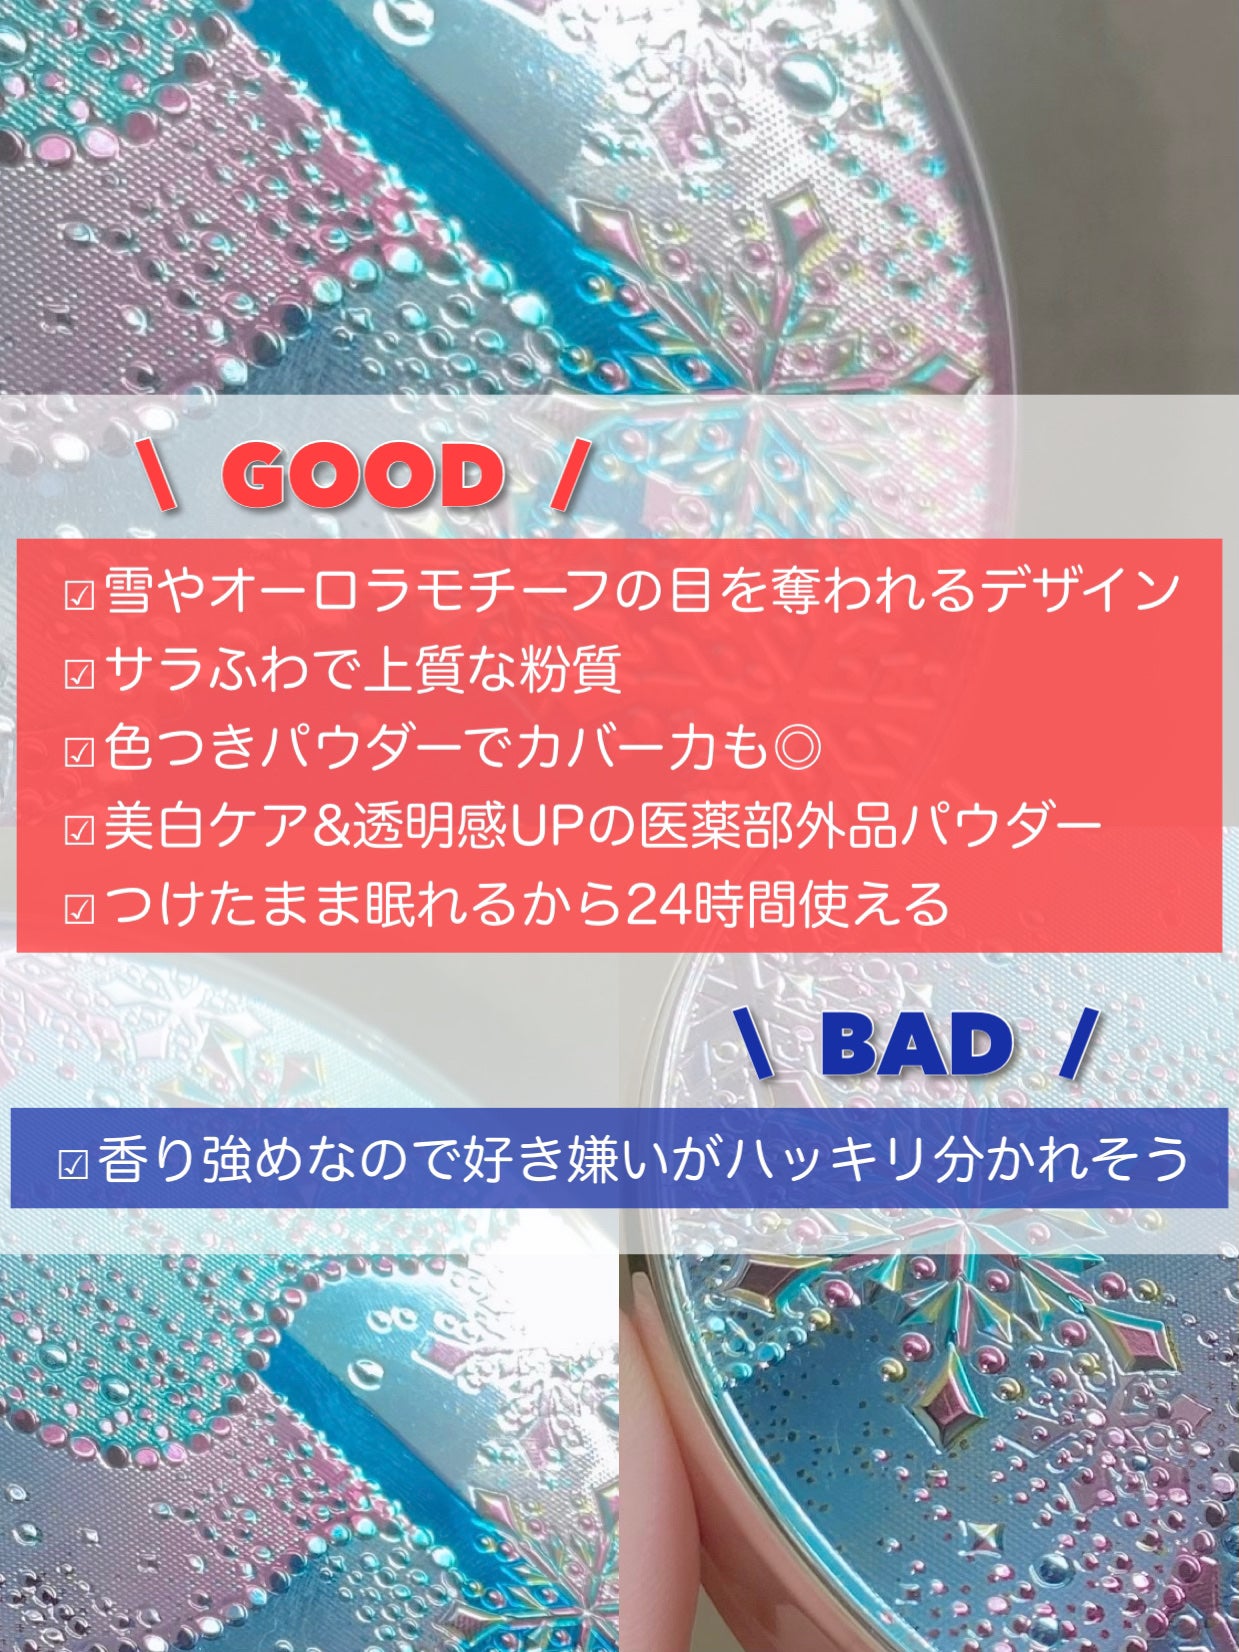

医薬部外品で成分最強 🤍4MSK→美白 💛グリチルリチン酸ステアリル→抗肌荒れ 自然にカバーしながら美白&スキンケアもできちゃう🥹👏✨ パフは2種類入っていておしろいとして使う時は薄いパフ 夜の素肌ケアとして使う時は厚いパフを使用
もっと見るおすすめアイテムスノービューティー×プレストパウダー
| 商品画像 | 商品情報 | 参考価格 | 評価 | ランキングIN | 特徴 | 商品リンク |
|---|---|---|---|---|---|---|
スノービューティー スノービューティー ブライトニング スキンケアパウダーA (医薬部外品) | 7,150円(編集部調べ) |
| フェイスパウダーランキング第74位 | つけてないような軽さなのに しっとり保湿感があり自然なツヤ肌に! 仕上がりはもちろんサラッサラです✌️ | 詳細を見る | |
スノービューティー スノービューティー2023 薬用美白スキンケアパウダー |
| プレストパウダーランキング第112位 | スノービューティーは朝晩どちらでも付けることが可能ですが、私はもっぱら朝に使います。 | 詳細を見る | ||
スノービューティー スノービューティー ブライトニング スキンケアパウダーA 2025 | 7,370円(編集部調べ) |
| フェイスパウダーランキング第67位 | ふんわりとナチュラルにカバー、ふわっと艶やかに仕上がる薬用スキンケアパウダー✨ | 詳細を見る |
プレストパウダーランキング
| 商品画像 | 商品情報 | 参考価格 | 評価 | ランキングIN | 特徴 | 商品リンク |
|---|---|---|---|---|---|---|
Elégance ラ プードル オートニュアンス | 9,900円 |
| フェイスパウダーランキング第1位 | セミマット仕上がりでふんわり毛穴もぼかしてくれます🥹✨ | 詳細を見る | |
NARS ライトリフレクティング プリズマティックパウダー | 6,380円 |
| フェイスパウダーランキング第2位 | 粉質は既存色と同じくサラサラで夏のこの時期特に本当に使える! | 詳細を見る | |
Dior ディオール バックステージ フェイス グロウ パレット | 6,600円 |
| フェイスパウダーランキング第3位 | このグロウの艶キラ感、たまらなく綺麗です♡ | 詳細を見る | |
muice スポットメンテパウダー | 1,045円 |
| フェイスパウダーランキング第6位 | 自然な立体感やツヤ感を出したい方、 マルチに使用できるパウダーを求めている方には 特におすすめできるかなと思います | 詳細を見る | |
キャンメイク マシュマロフィニッシュパウダー ~Abloom~ | 1,034円〜 |
| フェイスパウダーランキング第7位 | ほどよくトーンアップもして、お肌を綺麗に見せてくれます✨ | 詳細を見る | |
キャンメイク イルミネイティングフィニッシュパウダー ~Abloom~ | 1,034円〜 |
| フェイスパウダーランキング第8位 | 微細なパール入りでツヤっと仕上がりとても可愛い!!!ギラギラした仕上がりにならないのも🙆♀️ | 詳細を見る | |
Elégance エレガンス ラ プードル オートニュアンス リクスィーズ | 16,500円 |
| フェイスパウダーランキング第9位 | とにかく崩れず、毛穴もカバーしてくれる最高の一品。上品なラメがたまらない♥ | 詳細を見る | |
NARS ライトリフレクティングセッティングパウダー プレスト N | 5,830円 |
| フェイスパウダーランキング第11位 | 繊細なパールがお肌に馴染んで とっても綺麗に! | 詳細を見る | |
クレ・ド・ポー ボーテ プードルコンパクトエサンシエルn | 12,100円 |
| フェイスパウダーランキング第10位 | ふんわり光をまとったマットなサラサラ肌になって崩れにくい | 詳細を見る | |
Dior ディオールスキン フォーエヴァー クチュール ルミナイザー | 7,150円 |
| ベースメイクランキング第67位 | ハイライトが白浮きしてしまいがちなわたしですが、これは血色感与えながら艶々としてくれました😢 | 詳細を見る |
こひなたりりさんの人気クチコミ
それは…酵素洗顔パウダーを使う前に毛穴を開かせて洗浄力を最大限に引き出す!というシンプルだけど意外とみんなやっていない?方法です! 今回私が使った酵素洗顔パウダーはフルモア Sパウダーウォッシュ個包装でなくボトルタイプの酵素洗顔パウダーなので気になるところに必要な分だけ使えるのがありがたい! 毛穴ケアした後はしっかり保湿するのを忘れないで!効果があまり感じられなかった方はお風呂にタオルを持ち込んでお湯で温めてからしっかり絞ったタオルを顔に乗せてじっくりお湯に浸かった後やってみてください◎
もっと見る
4092
1733
- 2022.04.11
『ブラックヘッドを取る前に肌を温めて毛穴を開き本来の酵素洗顔の効果を引き出す』という方法です! 中でもファンケルディープクリア洗顔パウダーはQoo10メガ割での購入をおすすめ! 効果を感じられなかった方はケア前の「毛穴の開きが不十分」と考えられます また、「大切な日の当日の朝に黒ずみに気づいた…」「入浴している時間もおしい!」という方には前回ご紹介した蒸しタオルを使う方法をオススメします◎
もっと見る
2915
1814
- 2023.01.29
圧巻!KATEの単色アイシャドウ108色を全色スウォッチしました!KATEザアイカラー全108色のご紹介です!一つひとつにインパクトのあるネーミングがついていることで知られるKATEの単色アイシャドウをLIPSのハッシュタグイベント#KATE...
もっと見る
2382
2500
- 2024.01.06
黄味にも青みにも寄らないニュートラルカラーなので どんなアイメイクも合わせやすい◎ マスカラは #踊るさる さん買いした D-UPパーフェクトエクステンション マスカラ for カール チェリーブラウン まつ毛が抜けやすい私にとって お湯落ちなのもとっても嬉しいポイントで 一発で私の毎日メイク1軍マスカラに◎ リップの優しい印象を損なわないために 眉を明るめにしたくて選んだのは Visée リシェ カラーリングアイブロウマスカラ アイブロウパウダー ピンクブラウン 合わせたチークは キャンメイク パウダーチークス PW44 メロウピーチ 今回はデイリーメイクをテーマにしているので リアルにお仕事メイクで最近ずっと使ってる ウルミナプラス 生つや肌おしろい乳液 ナチュラルベージュ
もっと見る
1630
571
- 2022.05.04
ひとぬりでとろけてツヤがあふれだす リップモンスターツヤバース。唇から蒸発する水分を活用してとろツヤジェル膜に変化する独自技術で、落ちにくい。 トロトロなのに唇に乗せると嫌なベタつきはなくてムラにもならずにスルスル伸び広がってかつしっかりカラー感も楽しめる濃密な発色♡ これは艶リップ好きさん試してみて欲しい! もし一色しか選べないとしたら私の推しはG02 ピンクムーンの雫♡
もっと見る
1546
642
- 2024.10.13
既存色・リップモンスターとの比較アリ!ツヤバースの新色可愛すぎでしょ…KATEケイトリップモンスターツヤバースG04スパイダーリリー調香師G05ピンクロビンの泉のご紹介です!発売前から話題のツヤバース新色をオンライン先行発売でゲットしました!...
もっと見る
1491
768
- 2025.04.12
商品詳細情報スノービューティー スノービューティー ブライトニング スキンケアパウダーA (医薬部外品)
- ブランド名
- スノービューティー
- ランキングIN
- 全体ランキング年代別ランキングフェイスパウダー 10代 第74位フェイスパウダー 20代 第74位フェイスパウダー 30代 第74位フェイスパウダー 40代以上 第74位プレストパウダー 10代 第37位プレストパウダー 20代 第37位プレストパウダー 30代 第37位プレストパウダー 40代以上 第37位肌質別ランキング
- 容量・参考価格
- 本体: 7,150円
- レフィル: 4,400円
- バリエーション
- 本体
- レフィル
- 商品説明
- 24時間、肌に願いを。 つけた瞬間、自然なカバー&つや感で、 明るく透明感のある肌に。 Poin1:美白+抗肌あれ有効成分W配合 美白しながら、肌あれやニキビをどちらも防ぐ! Poin2:透明感メイク効果 くずれにくく、くすみにくい! 雪のような透明感のある肌が続く。 <セット内容> ・コンパクト本体 ・フェイスパウダー ・アミュレットポーチ ・スムースフィットパフ ・なめらかソフトパフ *美白化粧品は、メラニンの生成を抑え、シミ・そばかすを防ぎます。
- メーカー名
- 資生堂
- 発売日
- 2024/7/21
![LIPS[リップス] - コスメのクチコミ検索アプリ](https://cdn.lipscosme.com/assets/lips_logo_full_2022-bc7b4bc9dd66035bc5696b0d16bc3d38a7be357186656c039e68cc4cf21ae675.png)

私も今年は新調しようかと思ってるよ! 夏の鉄壁ベースメイクには必須だよね😂